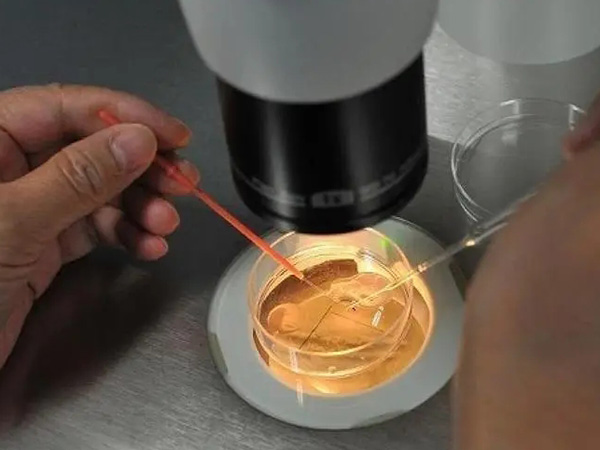

依使用者真實經歷、反饋整理甘肅省婦幼保健院生殖中心成功率資料參考,綜合疾病、方案、需求等多維度彙總甘肅省婦幼醫院試管嬰兒專家擅長,同步更新甘肅省婦幼醫院生殖醫生成功率實時排名,幫助更多人發現甘肅省婦幼醫院試管嬰兒專家誰最好。

甘肅蘭大一院和省婦幼試管成功率不可一概而論,哪個高來瞧
試管助孕技術是不孕不育人群實現生育的最後希望,但在選擇試管助孕前期的他們也更想要了解試管成功率的高低,想通過成功率的高低來做最後的決定。甘肅省內及周邊的大多數人群在蘭大一院和甘肅婦幼保健院間徘徊不定,今天就此來給大家進行相關解讀,方便大家選擇參考。甘肅省蘭大一院和甘肅婦幼對比甘肅省蘭大一院和甘肅婦幼保健院兩個醫院的試管助孕技術都是十分成熟且突出的,試管助孕的成功率均能達到70%左右,且都與國內試管...

海琳娜
11-08
甘肅婦幼院供卵試管價格一覽,讓你的助孕路不再迷茫!
在甘肅省婦幼保健院做一次供卵試管嬰兒一般是要不到15萬多的,最多就在12萬左右,而且還是做的第三代試管嬰兒。但如果患者一次供卵不成功,需要涉及到第二次、第三次等就非常有可能需要花費15萬多的價格。但總的來說,在甘肅省婦幼保健院做供卵試管花費都在6-12萬左右,極少人會超過這個價格,畢竟醫院也會對供卵者的卵子進行篩選,能保證其實健康的卵子。甘肅婦幼供卵試管費用詳情甘肅省婦幼保健院是省衛生廳直屬的非營...

董笑笑
07-06
甘肅省婦幼供卵試管費用、流程清單,大家最關心的問題答案都在這
目前甘肅省婦幼保健院已經開展了卵子凍融技術和一二三代試管嬰兒技術等人類輔助生殖專案,可幫助不孕不育症患者通過供卵試管助孕來到達生育目的,一般從夫妻二人的身體檢查一直到胚胎著床,整個流程要花費大概20000-100000元。甘肅省婦幼的供卵試管費用目前不孕不育患者在甘肅省婦幼做一次供卵試管嬰兒的價格大約為2-10萬,裡面包括了前期檢查、培育和移植的費用。另外如果使用的是第二代供卵試管嬰兒和第三代供卵...

紫不語
07-06
蘭州省婦幼保健院試管費用明細,三代比一代二代貴出一倍
在蘭州省婦幼保健院(甘肅省婦幼保健院)做試管嬰兒一般需要3-10萬元左右。具體花費多少需要看患者是做幾代試管,一般一代、二代費用有較為便宜在3-5萬元就能搞定,三代試管因為涉及到胚胎篩查,所以費用也會貴很多,在6-10萬元不等。如果是需要申請供卵、供精費用會更貴一些,供卵費用會在這個基礎上增加3-6萬元左右,供精會增加3000-5000元左右。蘭州婦幼試管費用明細表蘭州省婦幼保健院(甘肅省婦幼保健...

機動新撰組
07-06
走進甘肅省婦幼供卵試管全流程,登記排隊讓人望而卻步
甘肅省婦幼保健院供卵排隊的流程具體為先進行前期檢查、之後進行登記排隊,等待卵源,如果排到了就可以解凍卵源與男性的精子結合形成胚胎,最後再移植到女性身體內達到助孕的目的,一般目前卵源是比較稀缺的,需要等待很長時間才能夠申請上的,要有心理準備。甘肅省婦幼供卵排隊的流程供卵試管和普通試管嬰兒的區別在於不需要女性自己進行促排取卵階段,而是直接將捐贈者的卵源進行解凍,在和丈夫的精子再體外進行結合,培育成受精...

未見面就說再見
07-05
本地人談甘肅婦幼保健院供精試管費用,人均花費20萬是謠傳
甘肅省婦幼保健院是省衛生健康委直屬的非營利性公立保健醫療機構,是國家衛生健康委第一批授予的“愛嬰醫院”,該院承擔全省婦女兒童的保健、醫療、科研、教學、計劃生育技術指導、健康教育培訓、婦幼衛生資訊管理及婦幼保健領域對外交流等任務,本文圍繞甘肅婦幼保健院申請供精試管嬰兒的流程、費用以及條件給大家做個詳細的介紹,以便於每個有需求的家庭參考。關於甘肅婦幼保健院生殖中心甘肅省婦幼保健院生殖醫學中心成立於20...

女神候補生
07-04
甘肅省婦幼供精人授成功率超20%,年齡因素至關重要
目前不孕不育症患者在甘肅省婦幼保健院做一次人工授精的成功率大約為20%-30%,其中供精人授的妊娠率一般在25%-30%左右,只是要注意,該專案實際的資料與女性的卵子質量、子宮內膜的厚度和容受性等因素有關,因此建議大家僅將該專案的成功率作為參考。甘肅省婦幼供精人授成功率分析甘肅省婦幼保健院的一個週期供精人工授精的成功率一般在25%-30%左右,相對於夫精人工授精的妊娠率20%-25%要稍高一些,因...

白雪公主
07-04
細數甘肅省婦幼人工授精所需費用,二次手術花費少一半
甘肅省婦幼保健院的人工授精價格一般在3000-6000元左右,如果第一次不成功,就需要重新進入下一個人授週期,其中手術的費用大概為1000元,但要注意的是,每個女性的身體情況不同,精子注入的部位也就不一樣,因此具體開銷要根據實際為準。甘肅省婦幼人授的二次移植費用目前不孕不育症患者在甘肅省婦幼保健院做一次人工授精的開銷大概為3000-6000元,而針對第一次失敗做第二次手術的患者,大概要支付1000...

朱雅瓊
07-03
甘肅省婦幼保健院試管費用清單,詳扒每筆錢都花到哪裡去了
甘肅省婦幼保健院生殖醫學中心成立於2002年,2006年通過國家衛生部評審,是正式開展人類輔助生殖技術的專業醫療機構,由此很多打算赴甘肅省婦幼保健院做試管嬰兒的人群也充滿了各種疑問,這裡圍繞甘肅省婦幼保健院試管嬰兒費用、具體收費標準、技術水平等收集,整理成文,為更多不孕不育家庭在醫院選擇上提供參考。2023甘肅省婦幼保健院試管嬰兒收費明細一般在甘肅省婦幼保健院做試管嬰兒的全過程包括夫妻雙方全面身體...

章明基
07-03
盤點甘肅省婦幼生殖科醫生,最擅長三代試管的僅兩位
甘肅省婦幼保健院生殖中心中專家醫師有倪亞莉、安錦霞、丁仲軍、楊傑、馮帆、高喜紅。這些專家做試管移植的效果都是比較好的,並且具有多年豐富的臨床經驗,近些年幫助當地以及周邊地區的不孕不育患者成功實現生兒育女的夢想,得到了患者們的一致好評。甘肅省婦幼的醫生推薦目前在甘肅省可以進行試管治療的醫院還是比較少的,只有四家,而其中的甘肅省婦幼保健院對患者來說是比較不錯的一個選擇,目前該醫院開展了第一代、第二代、...

韓東東
07-03